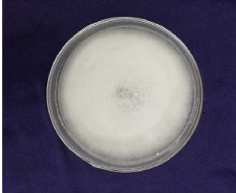

Original Research Papers

Esta obra está bajo una Licencia Creative Commons Atribución 4.0 Internacional.
Abstract: Anthracnose is one of the most destructive fungal diseases caused by Colletotrichum gloeosporoides in yard long bean, leading to complete crop loss at all stages and its parts like hypocotyls, stem, peduncle, flowers, leaves and pods were seriously affected. Few bush type cowpea cultivars have been earlier identified as reliable sources of resistance while trailing types are susceptible, but high yielding. Breeding resistant varieties is suggested as the only practical strategy, especially under hot and humid condition. Fifty-yard-long bean genotypes belonging to bush, semi erect and pole types were screened against anthracnose disease through artificial inoculation under pot culture. The present study identified the resistant varieties of vegetable cowpea through artificial inoculation followed by detached leaf assay. Among the 50 varieties of yard long bean observed, Kanakamony, dual purpose yard long bean was found highly resistant with disease severity of 3.67% followed by Arimbra local.
Keywords: Anthracnose, Colletotrichum gloeosporoides , yard long bean.
INTRODUCTION
Yard long bean (Vigna unguiculata subsp. sesquipedalis (L.) Verdcourt), a trailing type of vegetable cowpea (2n= 24) is one of the most popular and remunerative vegetable crops traditionally grown in Kerala. Due to the favourable agro climatic conditions, the crop has gained much importance and has come to occupy a prime position among the vegetable crops raised in the state. But the production of vegetable cowpea is hindered by an array of diseases that cause growth suppression or death of plants, leading to reduction in yield and productivity. Sreeja (2014) conducted periodical survey in the potential cowpea growing areas of Thiruvananthapuram district and reported that among the six major fungal diseases, anthracnose was found to be the most predominant one (0-55%). Disease index ranged between 0 - 33.30 and considerable yield losses were attributable to the disease.
Anthracnose is a destructive fungal disease caused by Colletotrichum spp. In India, the incidence of anthracnose disease was first reported from Maharashtra (Rao, 1966). According to Emechebe and Lagoke (2002), all stages of the crop and its parts like hypocotyls, stem, peduncle, flowers, leaves and pods were seriously affected. Previous attempts to identify reliable sources of resistance have led to the identification of few bush type resistant cowpea (Kumar, 1999), as most of the trailing cultivars are susceptible to anthracnose, but high yielding compared to the bushy or semi-trailing types.
The disease is pan-tropical in distribution and is being widely recorded in regions where conditions are wet and humid. Once the infection is incited under favourable condition, its management using fungicides is difficult. Breeding resistant varieties is suggested as the only practical strategy, especially under hot and humid condition. The present study identified the resistant varieties of vegetable cowpea through artificial inoculation followed by detached leaf assay.
MATERIALS AND METHODS
Fifty yard-long bean genotypes belonging to bush, semi erect and pole types were screened against anthracnose disease through artificial inoculation under pot culture. Seeds of vegetable cowpea genotypes were collected from different parts of India, including the released varieties of SAUs and ICAR institutes and stored at refrigerated conditions for the study. The most virulent isolate of C. gloeosporoides was used for artificial inoculation (Fig. 1 1). To isolate the fungal spores for artificial inoculation, infected plant parts were collected from field, washed in tap water, and surface sterilised using 0.1% mercuric chloride followed by washing thrice with autoclaved distilled water.
The fungus was cultured in potato dextrose agar medium and mycelial growth was observed through microscope. All Petri dishes were incubated at room temperature (25±20C). Petri dishes were examined for the growth of the pathogen and the morphological characteristics were observed. Inoculum was prepared from secondary culture of 7 dayold culture, by scrapping off the mycelium and spores and suspended in 100 ml sterile distilled water.
Seven seeds each of fifty genotypes were sown in two pots. After the germination, five healthy seedlings were retained and excess thinned out. Artificial inoculation was done on 20 days old seedlings kept in pots inside the greenhouse. Each plant was sprayed with 20 ml of spore suspension of virulent strain of C. gloeosporoides having a concentration of 106 spores ml-1 by following serial dilution method. The plants were covered with moistened polythene covers to maintain high humidity (Fig. 2). Inoculated plants were observed daily for disease incidence. Observations on disease incidence were taken on three, five, seven, nine, fifteen, twenty, twenty-five and thirty days. Final observation was taken when the disease was well expressed. Disease severity was assessed using the scale 0-5 reported by Latunde and Dada (1990).
0. No infection
0.5. Hypersensitive spots on main stem only
1: Trace of infection – Small anthracnose lesions onmain stem, petioles of lower leaf only
2. Slight infection – Lesions on stem, petioles andbranches
3. Moderate infection – Advanced anthracnoselesions on stem, petioles, branches, veins on theabaxial surface of leaves
4. Severe – Advanced anthracnose lesions on stem,petioles, branches, leaves, veins and peduncles
5. Very Severe – Advanced anthracnose lesions onstem, petioles, branches, leaf veins, spreadinglesions on peduncle and pods
Based on the percentage of plant area infected, disease severity/ intensity was calculated using the following formula (Wheeler, 1969).
Per cent disease severity =
Per cent disease incidence was calculated by using the following formula.
Per cent disease incidence =
Based on the per cent disease severity, the genotypes were grouped into 5 categories as adopted by Rajkumar et al. (1995).

Five plants of the resistant genotype identified through artificial inoculation were grown in the field and detached leaf assay was done just before flowering to confirm resistance.
RESULTS
Observations on disease incidence were recorded at 10 days after infection. The infection was first observed in leaves, reddish brown streaks were very prominent on veins and veinlets. Prominent mildew symptoms were also observed on the leaf lamina (Fig. 3). Finally, leaves became chlorotic and detached from the infected plant. Reddish brown lesions were also developed on the stem. These individual lesions coalesced to form large sunken lesions and covered the whole stem causing drying up of the veins which is known as vine blackening. The pods were rottened, grey in colour, covered with black fruiting bodies of fungus. According to the visible symptoms, the plants were awarded disease scores. Among the 50 genotypes tested, Kanakamony, a dual purpose yard long bean variety was found to be highly resistant with disease severity of 3.67%, followed by Arimbra local with
Percent disease severity and disease reaction of yard long bean genotypes for anthracnose incidence

Fig. 1

Fig. 2

Fig. 3

Fig. 4
9.58% disease severity. TCR 55(78.91 %) was found to be highly susceptible followed by FH-7 (70.78 %) (Table 1). Among the genotypes evaluated, eight showed moderately resistant reaction from 13.90 to 23.40%. In the eighteen moderately susceptible genotypes, much difference could not be noticed in disease severity values and most of them were pole types. In detached leaf assay, the leaves of Kanakamony was symptomless, and the resistance was confirmed in vitro (Fig. 4).
DISCUSSION
Anthracnose is one of the most destructive fungal diseases caused by Colletotrichum gloeosporoides in yard long bean, leading to complete crop loss in all stages and its parts like hypocotyls, stem, peduncle, flowers, leaves and pods were seriously affected. C. gloeosporioides has a wide host range including Brassica campestris, legumes, pigeon pea, soybean, brinjal, pumpkin, cucumber, tomato, spinach, mung bean, broad bean, cowpea, etc. (Sharma and Kulshrestha, 2015). Symptomatology studies on anthracnose of cowpea was conducted by Sreeja (2014). The initial symptoms appeared as minute, circular to irregular spots on the leaves which later increased in size and turned light to dark brown in colour and coalesced together to form large, necrotic spots on the leaves with shot holes. On the stem and vines, symptoms appeared as spindle shaped lesions with light grey centre and reddish-brown margin which enlarge upto 10-12 mm in length. In the later stages, small, irregular deep-seated reddish-brown spots appear on the pods also. Isolation, characterization and identification of the pathogen revealed that Colletotrichum gloeosporioides was associated with anthracnose.
Adebitan and Olufajo (1998) reported that grain types exhibited better resistance to anthracnose. Artificial inoculation of fifty genotypes confirmed the resistance in Kanakamony, followed by Arimbra local, hence these varieties are valuable sources for anthracnose resistance breeding programme. Kanakamony is a dual-purpose cowpea (grain cum vegetable) belonging to the sub-species cylindrica. Shiny et al. (2015) reported that susceptible bush-type cultivar Pusa Komal and pole type cultivar Lola showed 100 and 68.80 % disease severity while the immune bush type cultivar Kanakamony was free from the symptoms and pole type Arimbra Local showed 8.80 % disease severity using SDS-PAGE. These results further support that Kanakamony is highly resistant to C. gloeosporoides causing anthracnose. Since fungicides and chemicals are not fully effective, the transfer of resistance from the cultivars to trailing types can only be a durable solution. Hence the results revealed that the highly resistant genotypes Kanakamony and Arimbra local could be recommended for crop improvement programmes in trailing type vegetable cowpea for enhancing the resistance to anthracnose.
Acknowledgments
Merin Elza George expresses her sincere gratitude to Kerala Agricultural University, India for the complete funding of this research work, which forms part of her Ph.D program in Vegetable Science.
References
Adebitan S.A. and Olufajo O. 1998. Field evaluation of cowpea (Vigna unguiculata) varieties for grain and fodder production and for multiple disease resistance in Nigeria. Ind. J. Agric. Sci., 68:152–154.
Emechebe, A.M. and Lagoke, S.T.O. 2002. Recent advances in research on cowpea diseases. In: Challenges and opportunities for enhancing sustainable cowpea production. IITA, Nigeria pp. 94-123.
Kumar, M. P. 1999. Anthracnose disease of vegetable cowpea [Vigna unguiculata ssp. sesquipedalis (L.) Verdcourt]. M.Sc. Thesis, Kerala Agricultural University, Thrissur.
Latunde Dada, A.O. 1990. Assessment of anthracnose disease in some cultivars of cowpea (Vigna unguiculata) caused by Colletotrichum lindemuthianum. J. Phythopathol., 130: 147- 156.
Rajkumar, G, Kalloo, and Pandey, P.K. 1995. Resistance in cowpea to Pseudocercospora. In: Paper, National symposium on recent developments in vegetable Improvement; 2-5 February, 1995, Raipur, p. 23.
Rao, V.G., 1966. An account of the market and storage diseases of fruits and vegetables in Bombay- Maharashtra (India). Mycopathologia et mycologia applicata, 28(1-2):165-176.
Sharma M and Kulshrestha S. 2015. Colletotrichum gloeosporioides: An anthracnose causing pathogen of fruits and vegetables. Biosci. Biotechnol. Res. Asia, 12: 1233-1246.
Shiny, A., Mathew, D., Nazeem, P.A., Abida, P.S., Mathew, S.K. and Valsala, P.A. 2015. Identification and confirmation of trailing-type vegetable cowpea resistance to anthracnose. Tropical Plant Pathol., 40: 169-175.
Sreeja, S.J. 2014. Integrated management of fusarium wilt and anthracnose (Vigna unguiculata subsp. sesquipedalis (L.) Verdcourt) using new generation fungicides. Ph.D (Ag) thesis, Kerala Agricultural University, Thrissur.
Wheeler, H. and Pirone, T.P. 1969. Pathotoxin-induced disease resistance in plants. Sci., 166: 1415- 1417.
